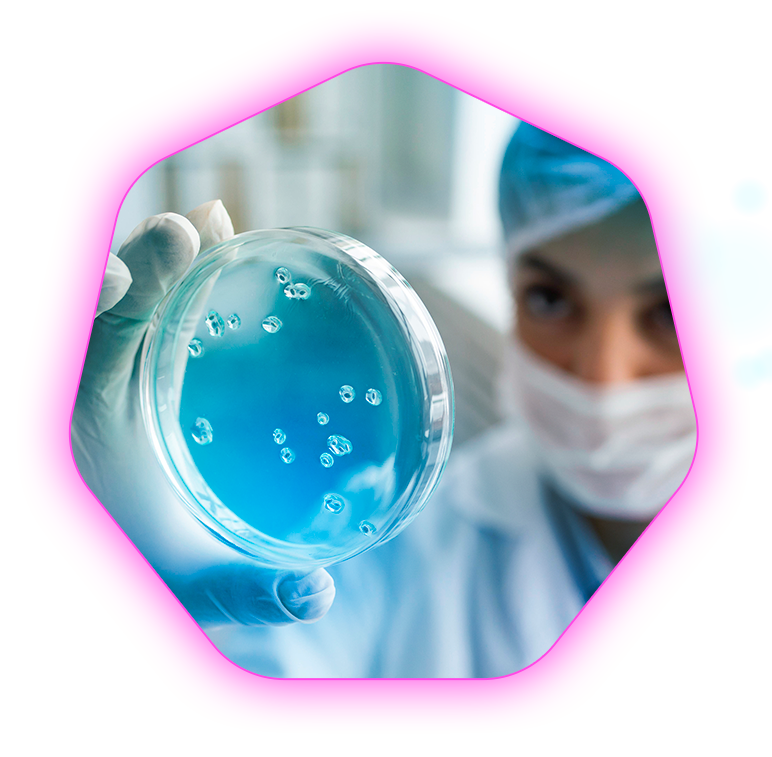
Bactepro R&D

Our Mission
“At Bactepro, we are committed to delivering science-backed antibacterial and hygiene solutions that protect families, businesses, and communities. Our mission is to provide high-quality disinfectants, household cleaners, and personal hygiene products that effectively eliminate 99.9% of germs, ensuring a safer, healthier environment for all.“
Our Expertise & Capabilities
With state-of-the-art manufacturing and a team of hygiene experts, Bactepro specializes in antibacterial formulations, disinfectant production, and hygiene innovation. Our advanced facilities and strict quality control ensure safe, effective, and high-performance solutions for homes, offices, and medical centers. We also offer OEM and private-label services, providing businesses with customized hygiene products tailored to their needs.



Innovation & Commitment
Innovation is at the core of Bactepro. We invest in cutting-edge research, eco-friendly formulations, and advanced technology to create next-generation hygiene solutions. Our commitment to safety, efficacy, and sustainability ensures superior germ protection without compromising on quality or environmental responsibility.


Professional & Regulatory Compliance
Bactepro adheres to strict global safety, quality, and regulatory standards, ensuring every product is tested, certified, and fully compliant with international health regulations. Our rigorous quality control and compliance measures guarantee safe, effective, and reliable hygiene solutions for homes, businesses, and healthcare facilities.
Bactepro: Elevating hygiene standards with innovation and trust.